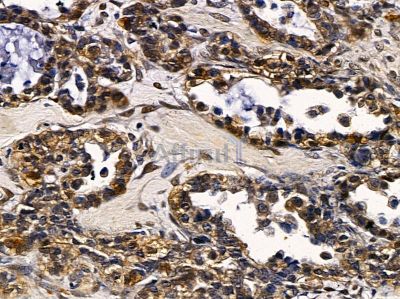
SRY Antibody - DF3242 at 1/100 staining human ovarian cancer by IHC-P.

SRY Antibody - #DF3242
| Product: | SRY Antibody |
| Catalog: | DF3242 |
| Description: | Rabbit polyclonal antibody to SRY |
| Application: | WB IHC IF/ICC |
| Reactivity: | Human, Rat |
| Prediction: | Pig, Dog |
| Mol.Wt.: | 25,37kD; 24kD(Calculated). |
| Uniprot: | Q05066 |
| RRID: | AB_2835622 |
Related Downloads
Protocols
Product Info
*The optimal dilutions should be determined by the end user. For optimal experimental results, antibody reuse is not recommended.
*Tips:
WB: For western blot detection of denatured protein samples. IHC: For immunohistochemical detection of paraffin sections (IHC-p) or frozen sections (IHC-f) of tissue samples. IF/ICC: For immunofluorescence detection of cell samples. ELISA(peptide): For ELISA detection of antigenic peptide.
Cite Format: Affinity Biosciences Cat# DF3242, RRID:AB_2835622.
Fold/Unfold
Essential protein for sex determination in human males; Sex determining region on Y; Sex determining region protein; Sex determining region Y; Sex-determining region Y protein; sox21b; SRXX1; SRXY1; SRY 1; SRY; SRY_HUMAN; Sry1; Sry3BI; SRYGENE; TDF; TDY; Testis determining factor; Testis Determining Factor on Y; Testis-determining factor; Transcription factor Sox-21-B;
Immunogens
A synthesized peptide derived from human SRY, corresponding to a region within the internal amino acids.
- Q05066 SRY_HUMAN:
- Protein BLAST With
- NCBI/
- ExPASy/
- Uniprot
MQSYASAMLSVFNSDDYSPAVQENIPALRRSSSFLCTESCNSKYQCETGENSKGNVQDRVKRPMNAFIVWSRDQRRKMALENPRMRNSEISKQLGYQWKMLTEAEKWPFFQEAQKLQAMHREKYPNYKYRPRRKAKMLPKNCSLLPADPASVLCSEVQLDNRLYRDDCTKATHSRMEHQLGHLPPINAASSPQQRDRYSHWTKL
Predictions
Score>80(red) has high confidence and is suggested to be used for WB detection. *The prediction model is mainly based on the alignment of immunogen sequences, the results are for reference only, not as the basis of quality assurance.
High(score>80) Medium(80>score>50) Low(score<50) No confidence
Research Backgrounds
Transcriptional regulator that controls a genetic switch in male development. It is necessary and sufficient for initiating male sex determination by directing the development of supporting cell precursors (pre-Sertoli cells) as Sertoli rather than granulosa cells (By similarity). In male adult brain involved in the maintenance of motor functions of dopaminergic neurons (By similarity). Involved in different aspects of gene regulation including promoter activation or repression (By similarity). Promotes DNA bending. SRY HMG box recognizes DNA by partial intercalation in the minor groove. Also involved in pre-mRNA splicing. Binds to the DNA consensus sequence 5'-[AT]AACAA[AT]-3'.
Phosphorylated on serine residues by PKA. Phosphorylation by PKA enhances its DNA-binding activity and stimulates transcription repression.
Acetylation of Lys-136 contributes to its nuclear localization and enhances its interaction with KPNB1. Deacetylated by HDAC3.
Poly-ADP-ribosylated by PARP1. ADP-ribosylation reduces its DNA-binding activity.
Nucleus speckle. Cytoplasm. Nucleus.
Note: Acetylation contributes to its nuclear localization and deacetylation by HDAC3 induces a cytoplasmic delocalization (PubMed:15297880). Colocalizes with SOX6 in speckles (PubMed:11818535). Colocalizes with CAML in the nucleus (PubMed:15746192). Colocalizes in the nucleus with ZNF208 isoform KRAB-O and tyrosine hydroxylase (TH) (By similarity).
DNA binding and bending properties of the HMG domains of human and mouse SRY differ form each other. Human SRY shows more extensive minor groove contacts with DNA and a lower specificity of sequence recognition than mouse SRY.
Belongs to the SRY family.
Restrictive clause
Affinity Biosciences tests all products strictly. Citations are provided as a resource for additional applications that have not been validated by Affinity Biosciences. Please choose the appropriate format for each application and consult Materials and Methods sections for additional details about the use of any product in these publications.
For Research Use Only.
Not for use in diagnostic or therapeutic procedures. Not for resale. Not for distribution without written consent. Affinity Biosciences will not be held responsible for patent infringement or other violations that may occur with the use of our products. Affinity Biosciences, Affinity Biosciences Logo and all other trademarks are the property of Affinity Biosciences LTD.